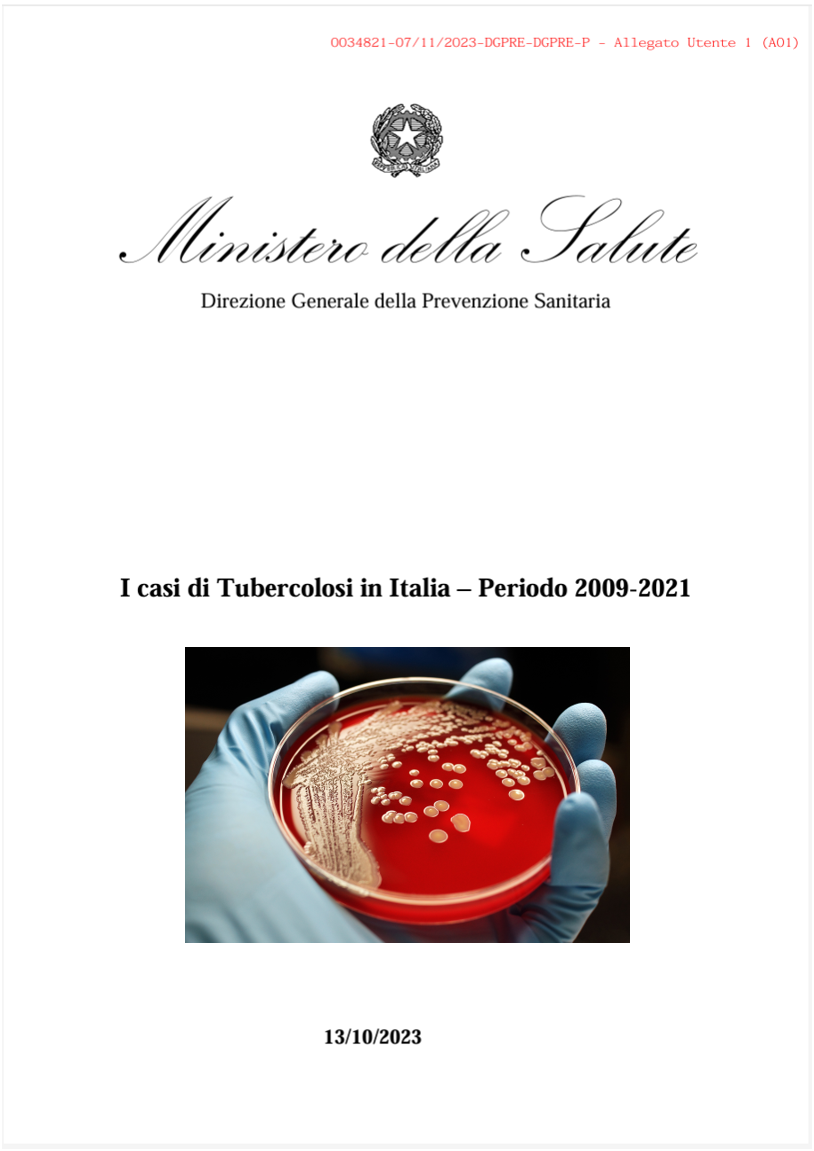
I casi di Tubercolosi in Italia   Periodo 2009 2021

I casi di Tubercolosi in Italia - Periodo 2009-2021
| ID 20983 | | Visite: 1801 | News | Permalink: https://www.certifico.com/id/20983 |
I casi di Tubercolosi in Italia - Periodo 2009-2021
ID 20983 | 15.12.2023
I casi di Tubercolosi in Italia - Periodo 2009-2021. A cura di Ministero della Salute - Anno 2023
Il rapporto è stato in parte realizzato nell’ambito dell’attività del Centro Nazionale per la Prevenzione e il Controllo delle Malattie (CCM). I dati sono stati estratti dal sistema nazionale di notifica dei casi di malattia infettiva con l’obiettivo di descrivere l’andamento temporale della tubercolosi (TBC) nel nostro Paese nel periodo 2009-2021. La distribuzione dei casi è stata rappresentata per macroarea geografica. I dati di notifica nazionali sono annualmente segnalati al Sistema di sorveglianza europeo (TESSy) del Centro per il Controllo delle Malattie (ECDC) di Stoccolma.
Periodo di riferimento 2009-2021
Fonte: Ministero della Salute
...
Collegati
Rischio di esposizione a micobatteri non tubercolari in ambienti di vita e di lavoro
La tubercolosi sul posto di lavoro: Rischi e prevenzione
Tags: News